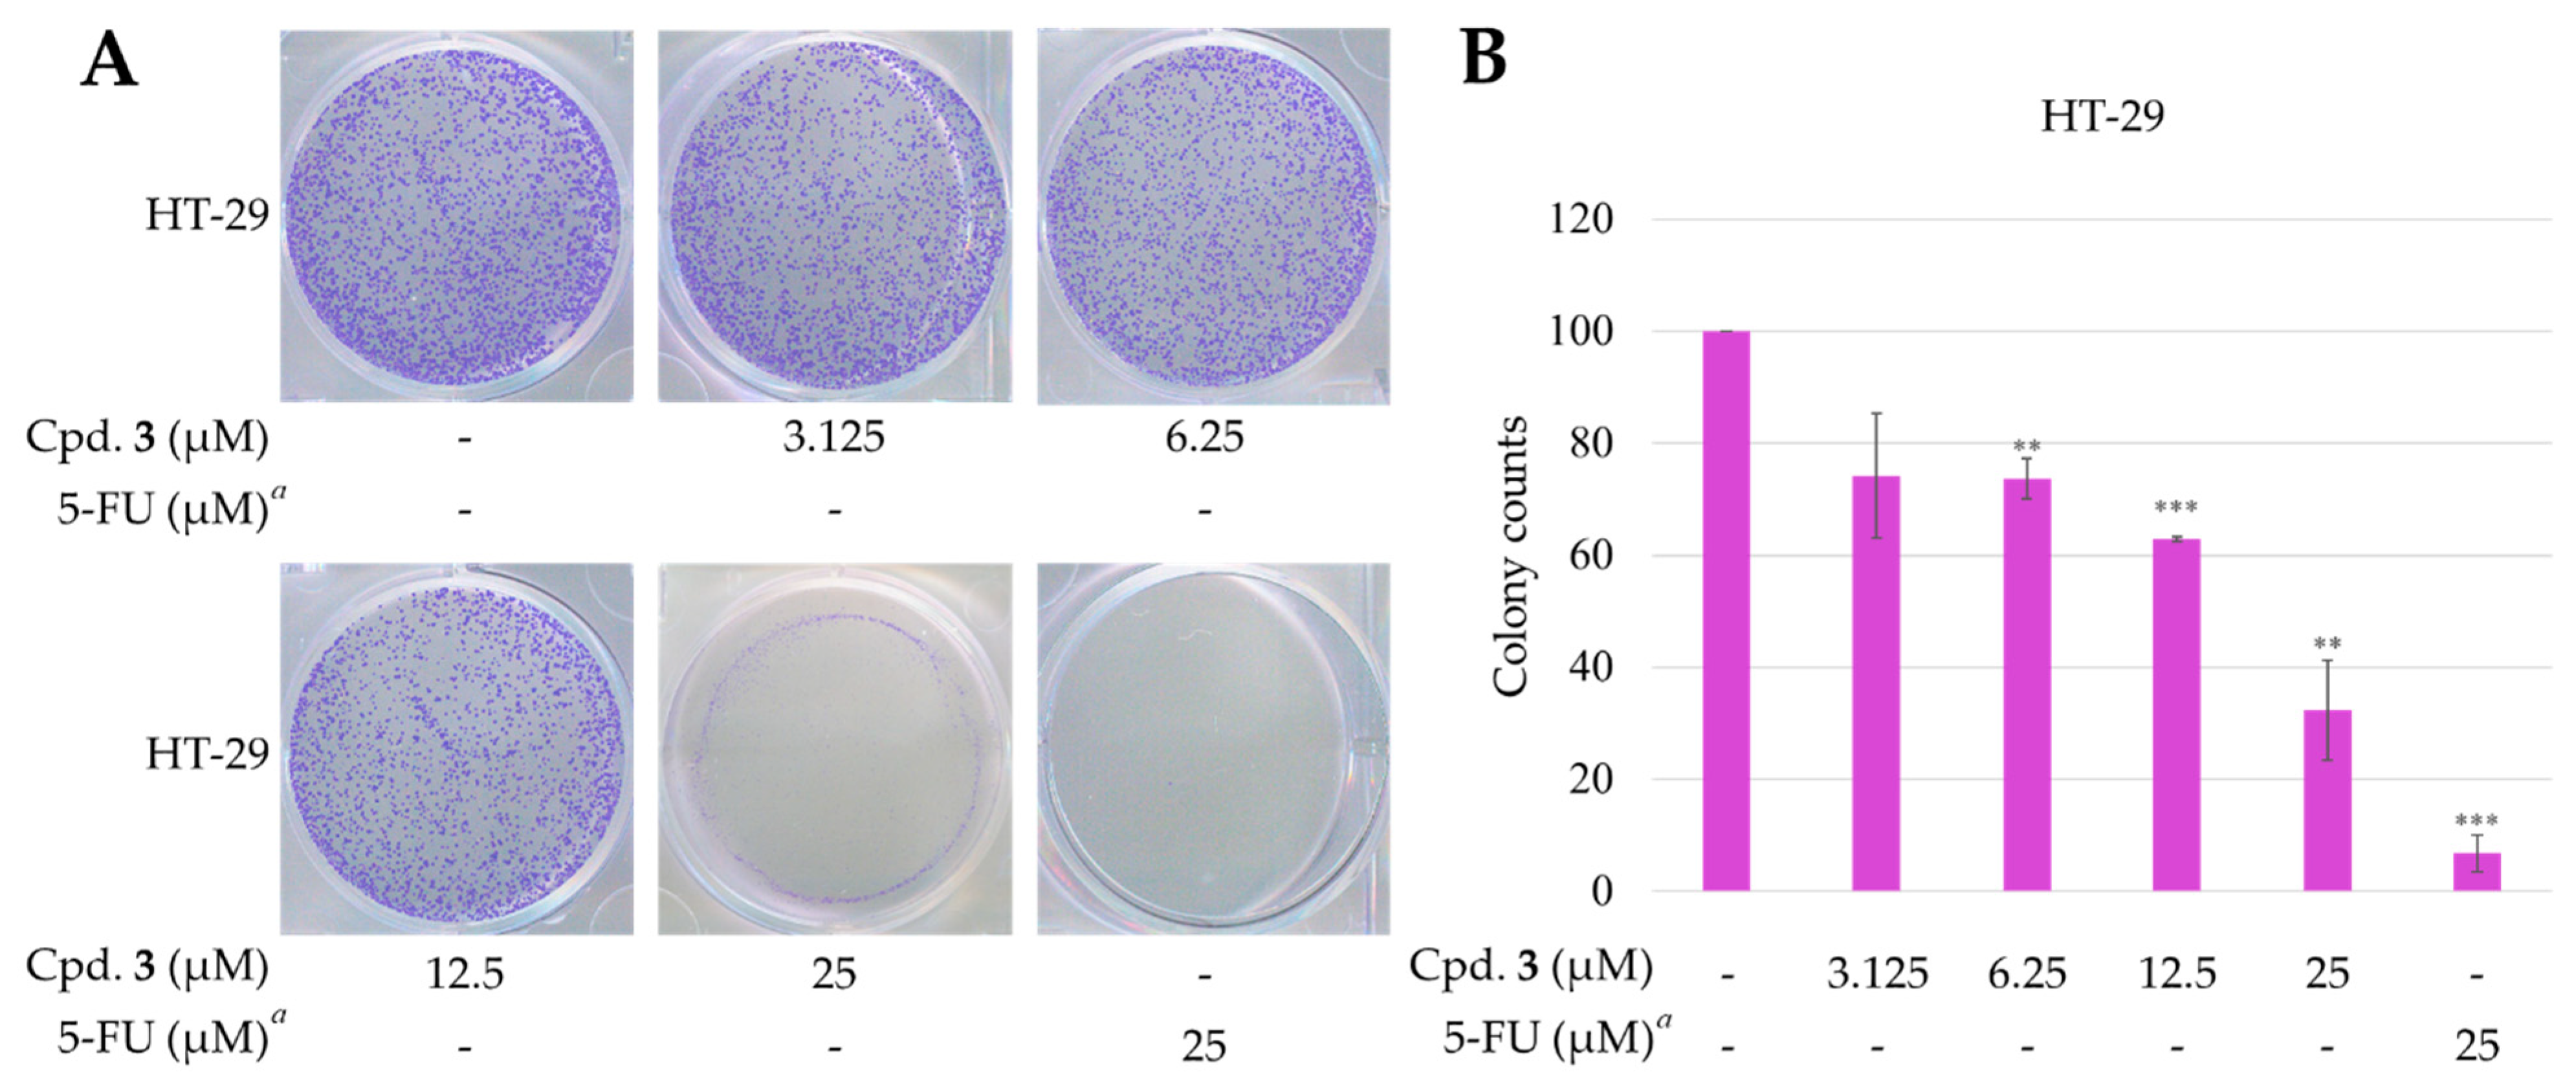
Marinedrugs 19 00408 g011 550

Anti-Cancer and Anti-Inflammatory Activities of Three New Chromone Derivatives from the Marine-Derived Penicillium citrinum
Abstract
:1. Introduction
2. Results and Discussion
2.1. Fermentation, Extraction, and Isolation
2.2. Structural Elucidation
2.3. Biological Studies
2.3.1. Inhibitory Activities on Neutrophil Pro-Inflammatory Responses
2.3.2. Cytotoxic Effects and Selectivity of Compounds 1–3
2.3.3. New Compound 3 Inhibited Proliferation of HT-29 Cells
2.3.4. Effects of Epiremisporine F (3) on Protein Expressions of Pro-caspase 3 and Cleaved Caspase 3 in HT-29 and A549 Cells
2.3.5. Effects of Compound 3 on Protein Expressions of Bax and Bcl-2 in HT-29 and A549 Cells
3. Materials and Methods
3.1. General Procedures
3.2. Fungal Material
Cultivation and Preparation of the Fungal Strain
3.3. Extraction and Isolation
3.4. Biological Assay
3.4.1. Preparation of Human Neutrophils
3.4.2. Measurement of O2•– Generation
3.4.3. Chemicals and Antibodies
3.4.4. Cells and Culture Medium
3.4.5. Cytotoxicity Assay
3.4.6. Clonogenic Assay
3.4.7. Western Blotting Analysis
3.4.8. Statistical Analysis
4. Conclusions
Supplementary Materials
Author Contributions
Funding
Institutional Review Board Statement
Informed Consent Statement
Data Availability Statement
Acknowledgments
Conflicts of Interest
References
- Blunt, J.W.; Copp, B.R.; Keyzers, R.A.; Munro, M.H.G.; Prinsep, M.R. Marine natural products. Nat. Prod. Rep. 2015, 32, 116–211. [Google Scholar] [CrossRef] [Green Version]
- Huang, G.L.; Zhou, X.M.; Bai, M.; Liu, Y.X.; Zhao, Y.L.; Luo, Y.P.; Niu, Y.Y.; Zheng, C.J.; Chen, G.Y. Dihydroisocoumarins from the mangrove-derived fungus Penicillium Citrinum. Mar. Drugs 2016, 14, 177. [Google Scholar] [CrossRef] [PubMed] [Green Version]
- Kong, F.; Carter, G.T. Remisporine B, a novel dimeric chromenone derived from spontaneous Diels-Alder reaction of remisporine A. Tetrahedron Lett. 2003, 44, 3119–3122. [Google Scholar] [CrossRef]
- Wakana, D.; Hosoe, T.; Itabashi, T.; Okada, K.; de Campos Takaki, G.M.; Yaguchi, T.; Fukushima, K.; Kawai, K.I. New citrinin derivatives isolated from Penicillium citrinum. J. Nat. Med. 2006, 60, 279–284. [Google Scholar] [CrossRef]
- Xia, M.W.; Cui, C.B.; Li, C.W.; Wu, C.J.; Peng, J.X.; Li, D.H. Rare chromones from a fungal mutant of the marine-derived Penicillium purpurogenum G59. Mar. Drugs 2015, 13, 5219–5236. [Google Scholar] [CrossRef] [PubMed]
- Zheng, C.J.; Huang, G.L.; Xu, Y.; Song, X.M.; Yao, J.; Liu, H.; Wang, R.P.; Sun, X.P. A new benzopyrans derivatives from a mangrove-derived fungus Penicillium citrinum from the South China Sea. Nat. Prod. Res. 2016, 30, 821–825. [Google Scholar] [CrossRef]
- Zheng, C.J.; Liao, H.X.; Mei, R.Q.; Huang, G.L.; Yang, L.J.; Zhou, X.M.; Shao, T.M.; Chen, G.Y.; Wang, C.Y. Two new benzophenones and one new natural amide alkaloid isolated from a mangrove-derived fungus Penicillium Citrinum. Nat. Prod. Res. 2019, 33, 1127–1134. [Google Scholar] [CrossRef]
- Chu, Y.-C.; Chang, C.-H.; Liao, H.-R.; Cheng, M.-J.; Wu, M.-D.; Fu, S.-L.; Chen, J.-J. Rare chromone derivatives from the marine-derived Penicillium citrinum with anti-cancer and anti-inflammatory activities. Mar. Drugs 2021, 19, 25. [Google Scholar]
- Witko-Sarsat, V.; Rieu, P.; Descamps-Latscha, B.; Lesavre, P. Halbwachs-Mecarelli, L. Neutrophils: Molecules, functions and pathophysiological aspects. Lab. Invest. 2000, 80, 617–653. [Google Scholar] [CrossRef] [Green Version]
- Ennis, M. Neutrophils in asthma pathophysiology. Curr. Allergy Asthma Rep. 2003, 3, 159–165. [Google Scholar] [CrossRef]
- Borregaard, N. The human neutrophil. Function and dysfunction. Eur. J. Haematol. Suppl. 1988, 41, 401–413. [Google Scholar] [CrossRef]
- Roos, D.; van Bruggen, R.; Meischl, C. Oxidative killing of microbes by neutrophils. Microbes Infect. 2003, 5, 1307–1315. [Google Scholar] [CrossRef] [PubMed]
- Vane, J.R.; Mitchell, J.A.; Appleton, I.; Tomlinson, A.; Bishop-Bailey, D.; Croxtall, J.; Willoughby, D.A. Inducible isoforms of cyclooxygenase and nitric-oxide synthase in inflammation. Proc. Natl. Acad. Sci. USA 1994, 91, 2046–2050. [Google Scholar] [CrossRef] [PubMed] [Green Version]
- Miyata, Y.; Sakai, H. Anti-cancer and protective effects of royal jelly for therapy-induced toxicities in malignancies. Int. J. Mol. Sci. 2018, 19, 3270. [Google Scholar] [CrossRef] [PubMed] [Green Version]
- Bommareddy, A.; Knapp, K.; Nemeth, A.; Steigerwalt, J.; Landis, T.; Vanwert, A.L.; Gorijavolu, H.P.; Dwivedi, C. Alpha-Santalol, a component of sandalwood oil inhibits migration of breast cancer cells by targeting the β-catenin pathway. Anticancer Res. 2018, 38, 4475–4480. [Google Scholar] [CrossRef] [PubMed]
- Kim, C.; Kim, B. Anti-cancer natural products and their bioactive compounds inducing ER stress-mediated apoptosis: A review. Nutrients 2018, 10, 1021. [Google Scholar] [CrossRef] [Green Version]
- Miyata, Y.; Matsuo, T.; Araki, K.; Nakamura, Y.; Sagara, Y.; Ohba, K.; Sakai, H. Anticancer effects of green tea and the underlying molecular mechanisms in bladder cancer. Medicines 2018, 5, 87. [Google Scholar] [CrossRef] [Green Version]
- Bao, B.; Zhang, X.-Y.; Dong, J.-J.; Xu, X.Y.; Nong, X.H.; Qi, S.H. Cyclopentane-condensed chromones from marine-derived fungus Penicillium oxalicum. Chem. Lett. 2014, 43, 837–839. [Google Scholar] [CrossRef]
- Zhang, F.; Li, L.; Niu, S.; Si, Y.; Guo, L.; Jiang, X.; Che, Y. A thiopyranchromenone and other chromone derivatives from an endolichenic fungus, Preussia africana. J. Nat. Prod. 2012, 75, 230–237. [Google Scholar] [CrossRef]
- Logashina, Y.A.; Palikova, Y.A.; Palikov, V.A.; Kazakov, V.A.; Smolskaya, S.V.; Dyachenko, I.A.; Tarasova, N.V.; Andreev, Y.A. Anti-inflammatory and analgesic effects of trpv1 polypeptide modulator aphc3 in models of osteo- and rheumatoid arthritis. Mar. Drugs 2021, 19, 39. [Google Scholar] [CrossRef]
- Lin, C.-H.; Chang, H.-S.; Liao, H.-R.; Chen, I.-S.; Tsai, I.-L. Triterpenoids from the Roots of Rhaphiolepis indica var. tashiroi and Their Anti-Inflammatory Activity. Int. J. Mol. Sci. 2013, 14, 8890–8898. [Google Scholar] [CrossRef]
- Barbagallo, M.; Sacerdote, P. Ibuprofen in the treatment of children’s inflammatory pain: A clinical and pharmacological overview. Minerva Pediat. 2019, 71, 82–99. [Google Scholar] [CrossRef]
- Irvine, J.; Afrose, A.; Islam, N. Formulation and delivery strategies of ibuprofen: Challenges and opportunities. Drug Dev. Ind. Pharm. 2018, 44, 173–183. [Google Scholar] [CrossRef]
- Grothey, A.; Sobrero, A.F.; Shields, A.F.; Yoshino, T.; Paul, J.; Taieb, J.; Souglakos, J.; Shi, Q.; Kerr, R.; Labianca, R.; et al. Duration of adjuvant chemotherapy for stage III colon cancer. N. Engl. J. Med. 2018, 378, 1177–1188. [Google Scholar] [CrossRef]
- Denise, C.; Paoli, P.; Calvani, M.; Taddei, M.L.; Giannoni, E.; Kopetz, S.; Kazmi, S.M.; Pia, M.M.; Pettazzoni, P.; Sacco, E.; et al. 5-fluorouracil resistant colon cancer cells are addicted to OXPHOS to survive and enhance stem-like traits. Oncotarget 2015, 6, 41706–41721. [Google Scholar] [CrossRef] [Green Version]
- Fu, Y.; Yang, G.; Zhu, F.; Peng, C.; Li, W.; Li, H.; Kim, H.G.; Bode, A.M.; Dong, Z.; Dong, Z. Antioxidants decrease the apoptotic effect of 5-Fu in colon cancer by regulating Src-dependent caspase-7 phosphorylation. Cell Death Dis. 2014, 5, e983. [Google Scholar] [CrossRef] [PubMed] [Green Version]
- Zhang, C.; Zhang, J.; Li, X.; Sun, N.; Yu, R.; Zhao, B.; Yu, D.; Cheng, Y.; Liu, Y. Huaier aqueous extract induces hepatocellular carcinoma cells arrest in S phase via JNK signaling pathway. Evid. Based Complement. Altern. Med. 2015, 2015, 171356. [Google Scholar] [CrossRef] [PubMed] [Green Version]
- Djafarzadeh, S.; Vuda, M.; Takala, J.; Jakob, S.M. Effect of remifentanil on mitochondrial oxygen consumption of cultured human hepatocytes. PLoS ONE 2012, 7, e45195. [Google Scholar] [CrossRef]
- Jelínek, M.; Balušíková, K.; Schmiedlová, M.; Němcová-Fürstová, V.; Šrámek, J.; Stančíková, J.; Zanardi, I.; Ojima, I.; Kovář, J. The role of individual caspases in cell death induction by taxanes in breast cancer cells. Cancer Cell Int. 2015, 15, 1–16. [Google Scholar] [CrossRef] [PubMed] [Green Version]
- English, D.; Andersen, B.R. Single-step separation of red blood cells. Granulocytes and mononuclear leukocytes on discontinuous density gradients of Ficoll-Hypaque. J. Immunol. Methods 1974, 5, 249–252. [Google Scholar] [CrossRef]
- Chen, L.C.; Liao, H.R.; Chen, P.Y.; Kuo, W.L.; Chang, T.H.; Sung, P.J.; Wen, Z.H.; Chen, J.J. Limonoids from the seeds of Swietenia macrophylla and their anti-inflammatory activities. Molecules 2015, 20, 18551–18564. [Google Scholar] [CrossRef] [Green Version]
- Babior, B.M.; Kipnes, R.S.; Curnutte, J.T. Biological defense mechanisms. The production by leukocytes of superoxide, a potential bactericidal agent. J. Clin. Investig. 1973, 52, 741–744. [Google Scholar] [CrossRef] [PubMed]
- Mosmann, T. Rapid colorimetric assay for cellular growth and survival: Application to proliferation and cytotoxicity assays. J. Immunol. Methods 1983, 65, 55–63. [Google Scholar] [CrossRef]
- Su, M.; Zhao, C.; Li, D.; Cao, J.; Ju, Z.; Kim, E.L.; Young-Suk, J.; Jung, J.H. Viriditoxin stabilizes microtubule polymers in SK-OV-3 cells and exhibits antimitotic and antimetastatic potential. Mar. Drugs 2020, 18, 445. [Google Scholar] [CrossRef] [PubMed]

| Compounds | Dihedral Angles | J3′, 4′α (Hz) | Dihedral Angles | J3′, 4′β (Hz) |
|---|---|---|---|---|
| (H3′-C3′-C4′-H4′α) | (H3′-C3′-C4′-H4′β) | |||
| 1 (2′S,3′S) | 54.5° | 4.7 | 173.7° | 8.4 |
| 2 (2′R,3′S) | 54.3° | 4.7 | 173.9° | 12.7 |
| 2 (2′S,3′S) | 54.3° | 5.9 | 174.0° | 11.5 |
| 3 (2′S,3′S) | 55.2° | 5.9 | 175.7° | 8.4 |
| Epiremisporine B (2′R,3′S) | 53.9° | 5.4 | 173.5° | 12.7 |
| Epiremisporine B (2′S,3′S) | 54.7° | 5.9 | 173.8° | 11.7 |
| Epiremisporine B1 (2′R,3′S) | 54.2° | 6.6 | 173.8° | 11.3 |
| Epiremisporine B1 (2′S,3′S) | 56.0° | 6.5 | 175.2° | 10.3 |
| Remisporine B (2′S,3′R) | 178.8° | 12.2 | 61.0° | 4.3 |
| Compounds | IC50 (μM) a |
|---|---|
| Epiremisporine F (1) | >50 |
| Epiremisporine G (2) | 31.68 ± 2.53 c |
| Epiremisporine H (3) | 33.52 ± 0.42 c |
| Ibuprofen b | 28.56 ± 2.73 c |
| Compounds | IC50 (μM) a | |
|---|---|---|
| HT-29 | A549 | |
| Epiremisporine F (1) | 44.77 ± 2.70 c | 77.05 ± 2.57 c |
| Epiremisporine G (2) | 35.05 ± 3.76 d | 52.30 ± 2.88 d |
| Epiremisporine H (3) | 21.17 ± 4.89 e | 31.43 ± 3.01 d |
| 5-FU b | 17.47 ± 1.67 e | 10.57 ± 1.89 d |
| Position | 1 | 2 (2’S) | 2 (2’R) | 3 |
|---|---|---|---|---|
| δH (J in Hz) | ||||
| 3 | 3.57 (dd, 10.5, 9.1) | 3.83 (t, 9.0) | 3.78 (dd, 9.0, 8.7) | 3.12 (d, 10.3) |
| 4 | 5.02 (d, 9.1) | 5.13 (d, 9.0) | 5.15 (d, 9.0) | - |
| 8 | 6.71 (br s) | 6.78 (br s) | 6.77 (br s) | 6.80 (br s) |
| 10 | 6.61 (br s) | 6.59 (br s) | 6.57 (br s) | 6.62 (br s) |
| 15 | 2.35 (s) | 2.37 (s) | 2.36 (s) | 2.38 (s) |
| 16 | 3.88 (s) | 3.75 (s) | 3.79 (s) | 3.91 (s) |
| 3′ | 3.08 (ddd, 10.5, 8.4, 4.7) | 3.01 (ddd, 11.5, 9.0, 5.9) | 2.90 (ddd, 12.7, 8.7, 4.7) | 3.05 (ddd, 10.3, 8.4, 5.9) |
| 4′α | 3.01 (dd, 18.7, 4.7) | 2.85 (dd, 16.7, 5.9) | 2.81 (dd, 15.8, 4.7) | 3.08 (dd, 18.9, 5.9) |
| 4′β | 2.87 (dd, 18.7, 8.4) | 2.62 (dd, 16.7, 11.5) | 2.43 (dd, 15.8,12.7) | 2.95 (dd, 18.9, 8.4) |
| 8′ | 6.70 (br s) | 6.71 (br s) | 6.70 (br s) | 6.64 (br s) |
| 10′ | 6.68 (br s) | 6.69 (br s) | 6.69 (br s) | 6.63 (br s) |
| 15′ | 2.42 (s) | 2.42 (s) | 2.41 (s) | 2.40 (s) |
| 16′ | 3.85 (s) | 3.87 (s) | 3.84 (s) | 3.85 (s) |
| 11-OH | 12.19 (s) | - | - | 12.14 (s) |
| 11-OMe | - | 3.91 (s) | 3.88 (s) | - |
| 2-OH | - | 4.53 (br s) | 4.41 (s) | - |
| 4-Me | - | - | - | 2.12 (s) |
| 2′-OMe | 3.11 (s) | - | 2.87 (s) | |
| 11′-OH | 12.42 (s) | 12.41 (s) | 12.36 (s) | 12.99 (s) |
| Position | 1 | 2 (2’S) | 2 (2’R) | 3 |
|---|---|---|---|---|
| δC, Type | ||||
| 1 | 170.2, C | 171.3, C | 172.8, C | 170.6, C |
| 2 | 91.1, C | 89.2, C | 91.3, C | 90.5, C |
| 3 | 44.0, CH | 48.2, CH | 47.0, CH | 54.1, CH |
| 4 | 37.8, CH | 36.7, CH | 35.9, CH | 47.4, CH |
| 5 | 169.9, C | 165.3, C | 165.1, C | 174.3, C |
| 7 | 157.2, C | 159.2, C | 159.2, C | 157.4, C |
| 8 | 108.5, CH | 110.7, CH | 110.7, CH | 108.9, CH |
| 9 | 147.2, C | 145.4, C | 145.2, C | 147.0, C |
| 10 | 113.0, CH | 108.3, CH | 108.4, CH | 112.7, CH |
| 11 | 160.8, C | 160.0, C | 160.0, C | 160.6, C |
| 12 | 108.7, C | 112.7, C | 112.8, C | 108.7, C |
| 13 | 179.2, C | 173.8, C | 173.7, C | 179.6, C |
| 14 | 118.5, C | 121.9, C | 121.2, C | 117.0, C |
| 15 | 22.2, CH3 | 22.1, CH3 | 22.1, CH3 | 22.2, CH3 |
| 16 | 53.3, CH3 | 53.0, CH3 | 53.5, CH3 | 53.4, CH3 |
| 1′ | 168.2, C | 170.0, C | 167.5, C | 167.6, C |
| 2′ | 107.9, C | 104.6, C | 105.9, C | 107.6, C |
| 3′ | 43.3, CH | 43.2, CH | 48.3, CH | 42.3, CH |
| 4′ | 25.4, CH2 | 26.3, CH2 | 27.5, CH2 | 25.5, CH2 |
| 5′ | 165.4, C | 166.7, C | 166.1, C | 165.1, C |
| 7′ | 155.9, C | 156.1, C | 156.1, C | 155.1, C |
| 8′ | 107.4, CH | 107.5, CH | 107.6, CH | 106.8, CH |
| 9′ | 147.4, C | 147.4, C | 147.5, C | 147.3, C |
| 10′ | 112.3, CH | 112.6, CH | 112.6, CH | 112.0, CH |
| 11′ | 160.3, C | 160.5, C | 160.5, C | 160.8, C |
| 12′ | 108.3, C | 108.5, C | 108.5, C | 108.7, C |
| 13′ | 180.5, C | 179.9, C | 179.8, C | 181.3, C |
| 14′ | 111.3, C | 112.7, C | 112.4, C | 114.8, C |
| 15′ | 22.4, CH3 | 22.4, CH3 | 22.4, CH3 | 22.3, CH3 |
| 16′ | 52.9, CH3 | 53.2, CH3 | 52.9, CH3 | 52.9, CH3 |
| 11-OMe | - | 56.3, CH3 | 56.3, CH3 | - |
| 4-Me | - | - | - | 28.4, CH3 |
| 2′-OMe | 52.3, CH3 | - | - | 51.3, CH3 |
Publisher’s Note: MDPI stays neutral with regard to jurisdictional claims in published maps and institutional affiliations. |
© 2021 by the authors. Licensee MDPI, Basel, Switzerland. This article is an open access article distributed under the terms and conditions of the Creative Commons Attribution (CC BY) license (https://creativecommons.org/licenses/by/4.0/).
Share and Cite
Chu, Y.-C.; Chang, C.-H.; Liao, H.-R.; Fu, S.-L.; Chen, J.-J. Anti-Cancer and Anti-Inflammatory Activities of Three New Chromone Derivatives from the Marine-Derived Penicillium citrinum. Mar. Drugs 2021, 19, 408. https://doi.org/10.3390/md19080408
Chu Y-C, Chang C-H, Liao H-R, Fu S-L, Chen J-J. Anti-Cancer and Anti-Inflammatory Activities of Three New Chromone Derivatives from the Marine-Derived Penicillium citrinum. Marine Drugs. 2021; 19(8):408. https://doi.org/10.3390/md19080408
Chicago/Turabian StyleChu, Yi-Cheng, Chun-Hao Chang, Hsiang-Ruei Liao, Shu-Ling Fu, and Jih-Jung Chen. 2021. "Anti-Cancer and Anti-Inflammatory Activities of Three New Chromone Derivatives from the Marine-Derived Penicillium citrinum" Marine Drugs 19, no. 8: 408. https://doi.org/10.3390/md19080408
APA StyleChu, Y.-C., Chang, C.-H., Liao, H.-R., Fu, S.-L., & Chen, J.-J. (2021). Anti-Cancer and Anti-Inflammatory Activities of Three New Chromone Derivatives from the Marine-Derived Penicillium citrinum. Marine Drugs, 19(8), 408. https://doi.org/10.3390/md19080408

